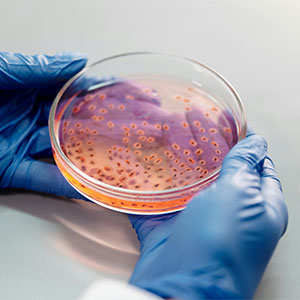

Join the Fun!
Join 1.2 million Panda readers who get the best art, memes, and fun stories every week!
Thank you!
You're on the list! Expect to receive your first email very soon!
Get our best stories, memes and art every week. Join a thriving community and brighten your day!
We value your inbox – it's 100% free, and you can unsubscribe anytime with one click.

A girl
Community Member

Grandma, retired information security professional. I garden, make really bad puns, snort when I laugh really hard and enjoy BP because it's pretty funny and BPs are generally pretty kind.






unfit_spartan_baby reply
One time my uncle put ranch dressing on a dry-aged NY strip steak that cost 70$.

funky_grandma reply
My sister-in-law worked on a ski hill. One week there was a promotion by a company where they would blow up big inflatables (like the big gorillas you see in car lots). She had seen them blow them up and deflate them for days, so she knew what the deflated ones looked like. One day she was leaving work and one of these deflated mascot thingies was right behind her car. My sister-in-law has never stolen anything in her entire life, but at that moment she decided out of the blue that she wanted that blow-up. She plopped it in the back and drove home. When I came to visit a couple weeks later she was freaking out about it. She asked me if I wanted it, just to get the evidence out of her house. That is the story of how I came to own a 2-story-high inflatable cow.


















unfit_spartan_baby reply
One time my uncle put ranch dressing on a dry-aged NY strip steak that cost 70$.

funky_grandma reply
My sister-in-law worked on a ski hill. One week there was a promotion by a company where they would blow up big inflatables (like the big gorillas you see in car lots). She had seen them blow them up and deflate them for days, so she knew what the deflated ones looked like. One day she was leaving work and one of these deflated mascot thingies was right behind her car. My sister-in-law has never stolen anything in her entire life, but at that moment she decided out of the blue that she wanted that blow-up. She plopped it in the back and drove home. When I came to visit a couple weeks later she was freaking out about it. She asked me if I wanted it, just to get the evidence out of her house. That is the story of how I came to own a 2-story-high inflatable cow.



 Dark Mode
Dark Mode 

 No fees, cancel anytime
No fees, cancel anytime